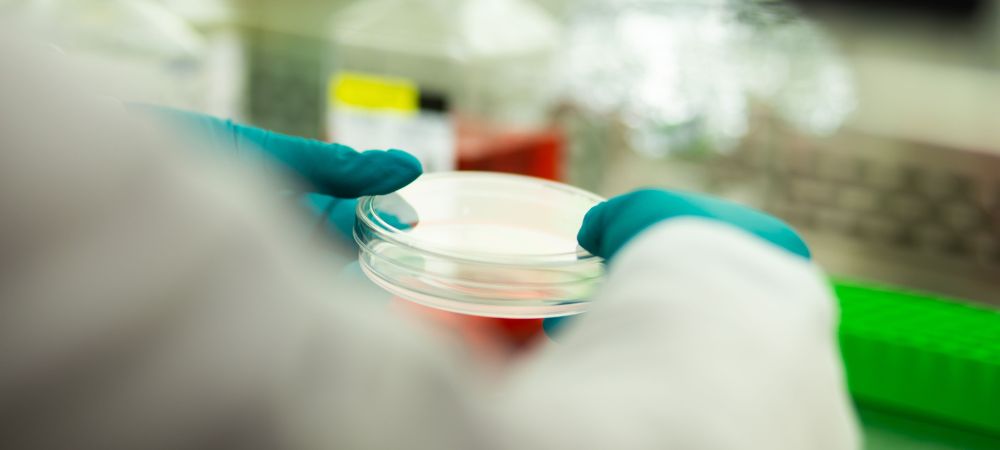
tissue culture

La Tissue Culture est une technique avancée de micropropagation végétale qui permet la reproduction de plantes dans un environnement contrôlé et stérilisé. Cette méthode permet d’isoler des parties d’une plante, telles que des cellules ou des tissus, et de les cultiver dans un milieu spécial pour développer de nouvelles plantes génétiquement identiques à l’original. Cette technique s’utilise largement dans l’agriculture et dans l’horticulture. Elle permet de produire des cultures à haut rendement, résistantes aux maladies et présentant des caractéristiques améliorées. Ci-dessous, découvrez tout ce qu’il faut savoir sur la culture tissulaire.
Qu’est-ce que la Tissue Culture ?
La culture tissulaire désigne la méthode de propagation aseptique qui permet la prolifération de cellules, de tissus ou d’organes végétaux dans des conditions stériles. Ce processus a lieu dans des conditions de laboratoire contrôlées, permettant le développement complet de plantes à partir de petites sections de tissus.
Origine de la culture tissulaire
L’origine de la culture tissulaire remonte à 1885, lorsque des scientifiques tels que Wilhelm Roux, un biologiste allemand, réussirent à maintenir en vie des cellules d’embryons de poulet pendant plusieurs jours. Toutefois, ce sont les travaux de Gottlieb Haberlandt, au début du XXe siècle, qui ont réellement jeté les bases de la culture de tissus végétaux. Haberlandt a été le premier à tenter de cultiver des cellules végétales isolées dans un milieu nutritif. Bien qu’il n’y soit pas parvenu à l’époque, sa vision et ses expériences ont été cruciales pour le développement futur de la technique.
Plus tard, en 1910, un chirurgien français améliora cette technique, définissant la culture tissulaire et mettant au point la technique. Au fil des ans, la technique a considérablement évolué. Elle a apporté une contribution essentielle à la recherche et à la biotechnologie végétale.
C’est dans les années 1930 que la culture tissulaire a commencé à prendre de l’ampleur, grâce aux travaux des scientifiques Philip R. White et Frederick Campion Steward. White réussit à faire pousser des racines de tomates dans un milieu de culture. Steward, quant à lui, fut le premier à régénérer des plantes à partir d’une seule cellule.
Principes de base
Les principes de base de la culture tissulaire sont notamment les suivants
- Stérilisation : pour un environnement aseptique.
- Milieu de culture : pour fournir les nutriments nécessaires au développement des cellules.
- Conditions environnementales : conditions de lumière, de température et d’humidité à respecter rigoureusement.
Avantages de la Tissue Culture pour l’agriculture
La culture de tissus végétaux présente de multiples avantages, tels que la production de plantes exemptes de maladies et la production à grande échelle dans des espaces restreints. Cette technique est essentielle dans la propagation des variétés de cannabis, où l’on recherche l’homogénéité et une qualité supérieure.
Différences entre Tissue Culture et clonage
| Clonage de plantes | Tissue Culture |
| Méthode de reproduction asexuée consistant à prélever une bouture d’un pied mère et à la cultiver pour développer une nouvelle plante génétiquement identique. | Technique de reproduction végétale impliquant la culture de cellules, de tissus ou d’organes végétaux dans un milieu de culture contrôlé afin de produire des plantes identiques à la plante mère. |
| Conserve la même génétique que le pied mère. | Elle permet de produire des plantes génétiquement identiques à partir de cellules ou de tissus sélectionnés. |
| Relativement facile et largement utilisé dans la propagation des plantes. | Plus complexe que le clonage traditionnel, il requiert un équipement spécialisé et des connaissances techniques avancées. |
| Produit des copies exactes de la plante mère. | Permet la multiplication rapide des plantes dans un environnement contrôlé. |
| Les plantes clonées peuvent hériter de la résistance ou des faiblesses du pied mère. | Contribue à renforcer la résistance des plantes aux maladies et au stress environnemental en sélectionnant des tissus sains et vigoureux pour la propagation. |
Utilisations de la culture tissulaire dans le domaine du cannabis
La micropropagation dans la culture de cannabis par culture tissulaire offre une opportunité révolutionnaire de standardiser et d’optimiser la production. La tissue culture permet aux producteurs de stabiliser un grand nombre de clones de cannabis identiques à partir du même pied mère. Ils garantissent ainsi l’homogénéité et la qualité constante de leurs récoltes. En outre, cette technique peut contribuer à la conservation de souches rares et à la création de nouvelles variétés possédant des caractéristiques recherchées. Voici quelques-unes des applications de cette technique :
Multiplication clonale
La culture tissulaire permet une multiplication clonale très efficace des plantes de cannabis. En utilisant un seul morceau de tissu de la plante mère, il est possible de produire plusieurs clones identiques. Cette technique est essentielle pour maintenir la stabilité des souches présentant des caractéristiques telles que la puissance, le profil terpénique ou la résistance aux maladies. Les clones obtenus sont exempts de pathogènes, ce qui constitue un avantage significatif par rapport au clonage traditionnel.
Conservation de la génétique
La préservation de la génétique est essentielle pour protéger la diversité et le patrimoine génétique du cannabis. La culture tissulaire permet la préservation à long terme de génotypes uniques, conservant la génétique pure pendant des années. Ce résultat est obtenu grâce à la cryoconservation, où les échantillons de tissus sont stockés à des températures extrêmement basses. Cela permet d’interrompre pratiquement tous les processus biologiques.
Sélection et choix des variétés
La tissue culture joue un rôle clé dans le breeding et la sélection des variétés. Elle permet aux chercheurs et aux breeders de mettre au point des plantes présentant des caractéristiques spécifiques, augmentant ainsi la qualité et l’efficacité de leurs sélections. Par exemple, ils peuvent isoler des souches présentant une résistance accrue aux maladies ou des niveaux plus élevés de cannabinoïdes tels que le THC ou le CBD. Cela accélère le processus de sélection et permet d’obtenir des variations au sein de l’espèce. Ces avantages ont des répercussions positives à la fois pour le consommateur et pour l’industrie. Cette technique ouvre la voie à l’exploration de nouvelles combinaisons génétiques, contribuant ainsi à la diversité et à la personnalisation du produit final.
Avantages spécifiques pour le cannabis
Les avantages spécifiques de la culture tissulaire pour le cannabis sont les suivants :
- Multiplication efficace et fiable : de nombreuses plantes peuvent être obtenues à partir d’un petit tissu. Cela permet d’économiser de l’espace et des ressources.
- Amélioration de la santé des plantes : les plantes obtenues sont généralement exemptes d’agents pathogènes et de maladies. En effet, la culture tissulaire se déroule dans un environnement stérile.
- Conservation de la qualité génétique : conservation et multiplication de gènes rares sans variabilité génétique.
- Vitesse de production : accélération de la disponibilité des plantes pour le marché. Cette adaptation est particulièrement bénéfique face à la demande croissante de cannabis thérapeutique.
Comment réaliser une culture tissulaire
La tissue culture dans le cannabis, comme toute autre application biotechnologique, nécessite un équipement spécialisé et des procédures précises pour garantir le succès et l’efficacité du processus.
Matériel requis pour la Tissue Culture
Voici quelques-uns des matériels nécessaires à la tissue culture
- Hotte à flux laminaire : un espace de travail stérile est essentiel pour éviter la contamination des échantillons. La hotte à flux laminaire offre un espace propre grâce à un flux constant d’air filtré.
- Autoclave : cet équipement permet de stériliser les outils, les milieux de culture et d’autres matériaux. Il garantit un environnement exempt de micro-organismes pathogènes.
- Microscope : il permet d’observer et d’évaluer l’état des cellules et des tissus en culture. On peut alors procéder aux ajustements nécessaires.
- Incubateurs et chambres de croissance : fournissent les conditions environnementales contrôlées nécessaires à la croissance optimale des tissus, notamment la température, l’humidité et la lumière.
Culture tissulaire à l’aide d’un kit de Tissue Culture
Le Tissue Culture Kit d’Athena est un kit complet qui permet aux cultivateurs de tous niveaux de pratiquer la culture tissulaire. Ce système permet non seulement de préserver et d’améliorer la génétique, en éliminant les infections telles que le HPLVD. En outre, il offre la possibilité d’enraciner les plantes à votre convenance, ce qui vous donne un contrôle total sur la préservation des souches. Il comprend tous les outils nécessaires : un autoclave, une hotte à flux laminaire, ainsi qu’un schéma de travail étape par étape pour guider les utilisateurs et tous les accessoires requis.

Il comprend le milieu de culture Athena Roots Culture Media et les formules Shoots. Ils sont conçus pour favoriser une croissance saine des racines et des jeunes plants en ajoutant simplement de l’eau, assurant un processus simplifié et efficace. Ce kit offre un environnement stérile et contrôlé pour la tissue culture, représentant une avancée significative dans la culture du cannabis et la préservation génétique.
Procédures pour la culture tissulaire
Les étapes à suivre sont les suivantes :
- Sélection et préparation du pied mère : le processus commence par la sélection minutieuse de la plante mère. Celle-ci doit être exempte de maladies et présenter les caractéristiques souhaitées. Un petit échantillon de tissu est prélevé, généralement à l’extrémité d’une pousse ou d’une jeune feuille.
- Début de la culture : l’échantillon se place dans un milieu de culture stérile, fournissant les nutriments et les hormones nécessaires à la croissance. Cette étape est cruciale pour établir une culture saine et viable.
- Multiplication : une fois la culture établie, on prélèvera de petites portions afin de les transférer dans de nouveaux milieux de culture. Cela permet d’entamer la phase de multiplication clonale, produisant un grand nombre de plantes identiques.
- Enracinement : après la multiplication, on transfère les tissus dans un milieu de culture qui favorise le développement des racines, les préparant ainsi à la transition vers le sol ou vers un autre substrat.
- Acclimatation : avant de les transplanter dans leur environnement de culture final, il faut offrir aux plantes une période d’acclimatation pour s’adapter aux conditions extérieures et réduire le stress lié à la transplantation.
La culture tissulaire constitue donc un processus de clonage facile et efficace, à la portée de tous.


